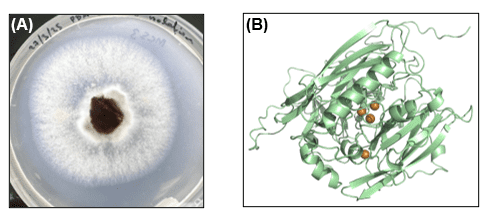
Panel A shows a fungal colony growing on a petri dish. Panel B shows a ribbon diagram of a protein structure with several orange spheres indicating important sites within the protein.

Annabel Whibley, Ngarita Warden (Bragato Research Institute), Wayne Patrick (Victoria University of Wellington)
Bragato Research Institute (BRI) and Victoria University of Wellington (VUW) are collaborating on a project to understand genetic diversity among the Botrytis strains that infect our fruit. We are also interested in characterising the laccase enzymes produced by these strains, so that we can explore new ways to remove them during winemaking.
In last summer’s pilot study, we received samples from six vineyards across Gisborne, Hawke’s Bay, and Marlborough, from which we were able to isolate and cultivate 11 different strains of Botrytis cinerea (Figure 1A). The BRI team then sequenced the entire genomes of these isolates to begin our dive into the genetic diversity of B. cinerea across New Zealand. Our widespread sampling approach is crucial to the project to understand the complex diversity of the laccases from the Botrytis strains that infect your grapes.
In parallel, the VUW team has focused on the main laccase from B. cinerea, isolated from an infected bunch of Gisborne Chardonnay fruit. We established protocols to purify this enzyme and measure its activity in vitro. We also modelled the atomic structure of the enzyme (Figure 1B), which allows us to predict the effects of the strain-specific differences we are seeing in the genome data.
Figure 1. Characterising Botrytis cinerea and its laccases. (A) Individual infected fruit (centre) were used to culture pure samples of B. cinerea (fuzzy mat) on agar plates. (B) Molecular models of laccase enzymes are guiding our biochemical analyses. The major laccase from a Gisborne isolate is shown, with the enzyme depicted as a green ribbon and the copper ions it binds (which are required for activity) shown as brown spheres.
This pilot study has been invaluable for building our pipeline, from isolating clonal strains of B. cinerea from infected fruit to genome analysis, to purifying individual laccase enzymes for biochemical characterisation. Now that we have established the project, we are excited to see where it goes next. Our current focus is on expanding our sampling to include more vineyards and grape varieties, and to use our genome sequencing data to guide our investigation of the other two major laccases produced by B. cinerea.
Call for samples
Now in our second year, we are calling for 2026 samples of botrytised fruit to better understand varietal and geographic diversity and to help guide future management strategies. We are particularly interested in receiving samples from multiple regions, which will enable us to see the diversity in B. cinerea across the length of New Zealand. If you can contribute, please see this letter with more information and instructions.
If you have questions, please contact Wayne Patrick at wayne.patrick@vuw.ac.nz.

